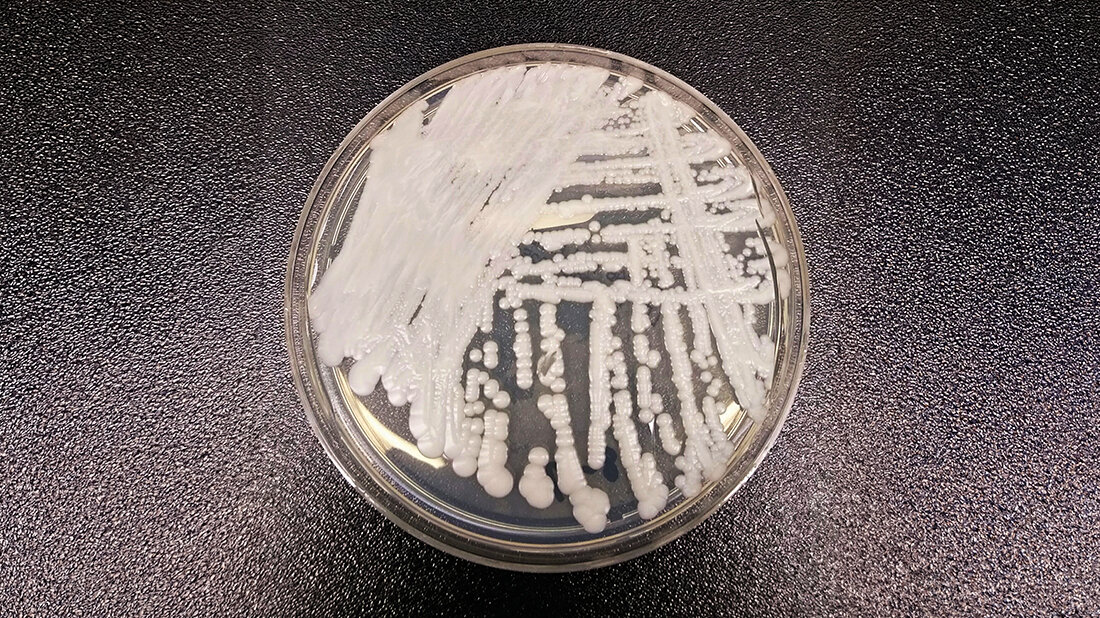
Petrischale mit Candida auris

Candida (Candidozyma) auris
Betroffen von den Kolonisationen und Infektionen sind meist Patientinnen und Patienten auf Intensivstationen und auf hämatologisch-onkologischen Stationen. Brandverletzte Patientinnen und Patienten haben ebenfalls ein erhöhtes Risiko einer Pilzbesiedlung und speziell einer C.-auris-Besiedlung ihrer Brandwunden, da die geschädigte Haut dem Erreger Möglichkeiten der Anheftung bietet. Zugleich wird die bakterielle Konkurrenzflora bei diesen Patientinnen und Patienten meist durch die Gabe von Breitspektrumantibiotika beseitigt, sodass die Hefepilze sich ungehindert ausbreiten können. Schwere invasive Weichgewebeinfektionen und Sepsis können die Folge sein. Ein kürzlich publizierter Ausbruch zeigt die Probleme einer Elimination des Erregers von einer Intensivstation [1].
Entnommen aus MT im Dialog 04/2026
Dann nutzen Sie jetzt unser Probe-Abonnement mit 3 Ausgaben zum Kennenlernpreis von € 19,90.
Jetzt Abonnent werden